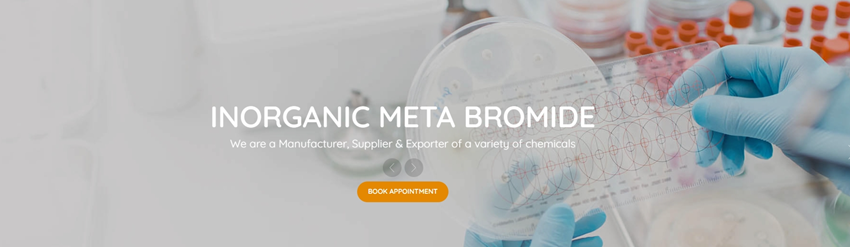

Current Location: Manufacturer >> Sontara Organo Industries
COMPONY INTRODUCTION
Enterprise Certification:
Learn more about us >
|
Sontara Organo Industries was established in the year 1971, and today, we are counted amongst the premium manufacturers and exporters in the industry.We manufacture a wide range of Aliphatic Esters, Inorganic Meta Bromide, Aliphatic Amine Hydrochloride, Inorganic Bromide, Aromatic Bromide, Lithium Compounds, Organic Bromide, Aromatic Compound, etc.We are also first Indian commercial producers of 1bromo 3 chloropropane and 3-Dimethyl amino-1-propylchloride hydrochloride. Production started in 1980.Sontara Organo Industries is a leading enterprise in the field of industrial and organic chemicals. We are a Manufacturer, Supplier & Exporter of a variety of chemicals. The company situated in Ambernath, Maharashtra (India) based partnership company is currently managed by Mr. Mukesh B Parekh.Our business operations are led by an experienced team of professionals who make sure that all the activities are performed in a systematic and best possible way. Further, they ensure our products me...
|
|
|
Business Scope: We are specialty chemicals and intermediates manufacturers, also can do CRO Type of Enterprise: Manufacturer Location: India Founded Date: 2020-02-01 |
|
|
|
|
Contact Supplier
| Sontara Organo Industries | |
|---|---|
| Country: | India |
| Tel: | +919321312582 |
| Mobile: | +91 7977018332 +91 |
| E-mail: | info@sontaraorgano.com |
| WhatsApp: | Chat Now! |
| Skype: | Chat Now! |